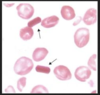

Chapter 14: Anemias Flashcards
In general, what are macrocytic vs. microcytic anemias each caused by?
- Macrocytic = abnormalities that impair maturation of erythroid precursors in the bone marrow
- Microcytic = disorders of hemoglobin synthesis (most often iron deficiency)
Which mean cell volume (fL) is indicative of micro- vs. macrocytic anemia?
- MCV <80 = microcytic
- MCV >100 = macrocytic
What does an elevated Red Cell Distribution Width (RDW) tell us?
- That marrow is pumping out reticulocytes (larger cells)
- Elevated RDW is a reactive phenomenon observed in states of anemia with a functioning marrow
Which changes are seen in red cells, white cells, and platelets with acute blood loss?
- Leukocytosis
- Reticulocytosis
- Thrombocytosis
A male or post-menopausal female presenting with iron-deficiency anemia is indicative of what until proven otherwise?
GI tract lesion
Hemolytic anemias share what 3 features?
- A shortened red cell life span below typical 120 days
- ↑ EPO levels and compensatory ↑ in erythropoiesis
- Accumulation of hemoglobin degradation products as part of red cell hemolysis
What ar the 3 principal clinical features of extravascular hemolysis?
- Anemia
- Splenomegaly
- Jaundice

Patients with extravascular hemolysis often benefit from what?
Splenectomy due to much of the pathologic destruction of RBC’s occurring in the spleen
What are the 5 main manifestations of intravascular hemolysis?
- Anemia
- Hemoglobin-emia
- Hemoglobin-uria
- Hemosiderin-uria
- Jaundice

In all types of uncomplicated hemolytic anemias, the excess serum bilirubin is of what type?
Unconjugated

What happens to the levels of serum haptoglobin with extra- and intravascular hemolysis?
- Extravascular = variably decreased as some Hgb escapes phagocytes
- Intravascular = becomes markedly reduced–> freeHgboxidizes tomethemoglobin
Regardless of the cause of type of hemolytic anemia what morphological changes are seen in the peripheral blood and BM?
- ↑ numbers of erythroid precursors (normoblasts) in the marrow
- Prominent reticulocytosis in the peripheral blood
With chronic hemolysis, elevated biliary excretion of bilirubin promotes what?
Formation of pigment gallstones (cholelithiasis)
Hereditary spherocytosis is an inherited disorder caused by intrinsic defects in what?
Red cell membrane skeleton –> cells are spheroid, less deformable, and vulnerable to splenic sequestration

What is the inheritance pattern of hereditary spherocytosis; prevalence is highest where?
Autosomal Dominant (75% of cases); highest in Northern Europe
What is the characteristic morphology of the red cells seen on smears in pt with hereditary spherocytosis?
Small, dark-staining (hyperchromic) red cell lacking central zone of pallor

Characteristc morphology of the spleen in hereditary spherocytosis?
Moderate splenomegaly (500-1000 gm)
Red cells of hereditary spherocytosis are abnormally sensitive to what; what is the MCHC finding?
- Osmotic lysis when incubated w/ hypotonic salt solution
- HS red cells also have ↑ MCHC, due to dehydration caused by loss of K+ and H2O
Characteristic clinical findings of hereditary spherocytosis are what; some may be asymptomatic but most will have what type of anemia?
- Splenomegaly + jaundice + anemia +/- gallstones
- CHRONIC hemolytic anemia of mild to moderate severity

Aplastic crises occurring in the setting of hereditary spherocytosis is often triggered by what?
Parvovirus B19 infection (ssDNA virus)
How is the anemia and its complications in hereditary spherocytosis treated?
Splenectomy
What are the most common triggers responsible for the episodic hemolysis seen with G6PD deficiency?
- Infections: viral hepatitis, pneumonia, and typhoid fever
- Drugs: ASA, diphenhydramine, antimalarials, sulfonamides, and nitrofurantoins
- Foods: including simple CHO’s, tonic water, sulfites (wine and dried fruit), and fava beans** (endemic in Mediterranean, ME, and Africa)

The acute intravascular hemolysis is greater in pt’s with which variant of G6PD deficiency?
Mediterranean variant

What is seen 2-3 days following exposure of G6PD-deficienct pt’s to oxidants?
Acute intravascular hemolysis marked by anemia, hemoglobinemia, andhemoglobinuria

Sickle cell disease is due to a point mutation at which codon of β-globin; causes the replacement of which AA’s?
6th codon of β-globin causing replacement of glutamate —> valine
Why do patients with hereditary persistence of HbF experience less severe sickle cell disease?
HbF inhibits polymerization of HbS even more than HbA
Why do individuals who are homozygous for HbS but also have co-existent α-thalassemia have decreased severity of disease?
- α-thalassemia reduces Hgb synthesis which ↓ MCHC
- ↑ MCHC levels facilitate sickling
What factor is responsible for the vascular occlusion seen most prominently in the spleen, bone marrow, and inflammed tissues in a pt with sickle cell disease?
- BM/Spleen = sluggish blood flow through microvascular beds
- Inflammed = slowed blood due to adhesion of leukocytes to activated endothelial cells and transudation of fluid thru leaky vessels
Which AA’s are swapped in the HbC variant?
Glutamic acid —> lysine (“lyCine”) in 6th AA of β-globin
How does the release of free hemoglobin from lysed sickle red cells contribute to vasoconstriction, ↑ platelet aggregation, stasis, sickling, and thrombosis?
Free Hbg can bind and inactivate NO, which is a potent vasodilator and inhibitor of platelet aggregation
Which crises due to vaso-occlusion is extremely common in children w/ sickle cell disease; how does it manifest?
- Painful bone crises and often difficult to distinguish from osteomyelitis
- Most frequently manifest as hand-foot syndrome or dactylitis of the bones of the hands or feet, or both

Up to 45% of males with sickle cell disease are affected by what after puberty?
Priapism –> may lead to hypoxic damage and ED
How does acute chest syndrome as a complication of sickle cell disease present?
Fever + cough + chest pain + pulmonary infiltrates

Sequestration crises occur in which pt’s with sickle cell disease and how does it manifest?
- Children w/ intact spleens
- Massive entrapment of sickle red cells leads to rapid splenic enlargement + hypovolemia, and sometimes shock
- May be fatal

A sudden worsening in the anemia of a patient with sickle cell disease should prompt you to consider what underlying cause?
Aplastic crises due to Parvovirus B19

Chronic hypoxia in children with sickle cell disease is responsible for impairment in what?
Growth and development, as well as organ damage affecting spleen, heart, kidney, and lungs

Sickling provoked by hypertonicity in the renal medulla causes damage and eventually leads to what?
Hyposthenuria (inability to concentrate urine) –> ↑ propensity for dehydration
What is the most common cause of death in adults vs. children w/ sickle cell disease?
- Adults = Acute Chest Syndrome
- Children = Haemophilus influenzae
How does the morphology of the spleen change from childhood to early adulthood in pt with sickle cell disease?
- Children have splenomegaly due to red pulp congestion caused by trapping of sickled cells in the cords and sinus
- Early adulthood will have autosplenectomy as chronic erythrostasis leads to splenic infarction, fibrosis, and progressive shrinkage
Leg ulcers are a common finding in which patients with sickle cell disease?
Adults
Which is more common and serious, Hgb C or Hgb SC disease?
Hgb SC is more common and severe

What is the distinctive morphology of Hgb C which may be seen on routine peripheral blood smear?
Crystalline form
The defects in globin synthesis that underlie thalassemia disorders cause anemia through what 2 mechanism?
- ↓ red cell production
- ↓ red cell life-span
*NOT primarily hemolysis*

How is β-globin synthesis affected in β0 mutations vs. β+ mutations; what is the most common underlying mutation for each?
- β0 mutation: absent β-globin synthesis; most commonly due to chain terminator mutation
- β+ mutation: reduced (but detectable) β-globin synthesis; most commonly due to splicing mutations

Impaired β-globin synthesis in β-thalassemia causes a deficit in HbA synthesis producing what type of red cells?
“Underhemoglobinized” hypochromic, microcytic red cells
What occurs to the unpaired α-chains seen in β-thalassemia; what is the proximal cause of most red cell pathology?
- Precipitate within red cell precursors, forming insoluble inclusions
- Prox. cause of red cell pathology is membrane damage caused by these inclusions; also undergo apoptosis
What are some of the complications due to ineffective erythropoiesis seen in severe β-thalassemia?
- Massive erythroid hyperplasia in marrow and extensive extramedullary hematopoiesis —> erosion of bony cortex + hepatosplenomegaly
- Metabolically active erythroid progenitors steal nutrients from already hypoxic tissues causing severe cachexia in untreated pt’s
- Suppresses hepcidin = ↑ iron absorption on top of repeat transfusions can lead to seconary hemochromatosis

β-thalassemia major is most common where?
Mediterranean countries, parts of Africa, and SE Asia
How soon after birth does the anemia of β-thalassemia major present?
6-9 months after birth as Hgb synthesis switches from HbF –> HbA

What are the major manifestations of bone seen in pt with untreated β-thalassemia major?
- Hypoxia –> ↑ EPO –> Expansion of marrow erodes existing cortical bone and induces new bone formation of the skull and face
- Giving rise to “crewcut” appearance on X-ray

Blood transfusions may improve the anemia and suppress complications related to excessive erythropoiesis in β-thalassemia, but may lead to what complications?
Cardiac disease and 2’ hemochromatosis from excessive iron overload = important cause of death
What is survival like in pt’s with β-thalassemia major who receive transfusions and iron chelation; what is the only therapy offering a cure?
- Transfusions + chelators = survival into the 3rd decade
- Hematopoietic stem cell transplantation = only cure

What are the levels of HbF and HbA2 like in β-thalassemia minor?
- ↑ levels of HbA2
- HbF levels are normal or sometimes slightly ↑ (will be ↑↑↑ in major)

Recognition of β-thalassemia minor (trait) is important for what 2 reasons?
- Superficially resembles the hypochromic microcytic anemia of iron deficiency
- Has implications for genetic counseling

Which value is diagnostically useful in women of childbearing age who are at risk for both β-thalassemia trait and iron deficiency?
HbA2 –> ↑ in β-thalassemia minor (trait)

Basophilic stippling seen on smears of β-thalassemia major are indicative of what?
Toxic injury to RBC’s

α-thalassemias are caused by what?
Inherited DELETIONS that result in reduced or asbent synthesis of α-globins (compared to β-thalassemias which are due to mutations)

How do the tetramers formed in infants with α-thalassemia differ from that of older children/adults?
- Infants form γ4 tetramers known as hemoglobin barts
- Older children/adults form β4 tetramers known as HbH

α-thalassemia trait is caused by deletion of how many α-globin genes and what 2 ways can this occur; which populations more affected?
- Deletion of 2 α-globin genes
- From single chromosome = α/α -/- = Asians
- From two chromosomes = α/- α/- = African, Asian

Clinically significant α-thalassemia is more common in children born to a parent with what type of halotype?
At least one parent with -/- halotype; more often seen in Asians

What is the clinical picture like in someone with α-thalassemia trait?
- Small red cells (microcytosis) + minimal or no anemia
- No abnormal physical signs
- HbA2 levels are normal or low
*Resembles β-thalassemia minor*
Hemoglobin H Disease (HbH) is caused by deletion of how many α-globin genes and is most common in which population?
- Deletion of 3 α-globin genes
- Most common in Asian populations

Why is there tissue hypoxia disproportionate to the level of hemoglobin in patients with HbH disease?
HbH has extremely ↑ affinity for O2
What is the anemia like in HbH disease and it resembles that of which β-thalassemia?
- Moderately severe anemia
- Resembles that of β-thalassemia intermedia
What is the most severe form of α-thalassemia called and is due to what?
- Hydrops fetalis
- Due to deletion of all 4 α-globin genes
- Excess γ-globin chains form hemoglobin barts that have such a high affinity for O2 that they deliver little to tissues
When does hydrops fetalis become evident and what must be done for survival of the infant?
- Fetal distress becomes evident during 3rd trimester
- Require intrauterine transfusions
- There will be lifelong dependence on blood transfusions for survival w/ the assoc. risk of iron overload
What is the only hemolytic anemia caused by an acquired genetic defect?
Paroxysmal Nocturnal Hemoglobinuria (PNH)
What is the inheritance pattern and dysfunctional enzyme in Paroxysmal Nocturnal Hemoglobinuria (PNH)?
- X-linked and subject to lysonization (random inactivationof one X chromosome in cells of females)
- Mutation of PIGA which encodes enzyme essential for GPI-linked proteins that regulate complement activity

In Paroxysmal Nocturnal Hemoglobinuria (PNH) blood cells are deficient in which 3 GPI-linked proteins that regulate complement; which is most important?
- Decay-accelerating factor (CD55)
- Membrane inhibitor of reactive lysis (CD59) = most important; potent inhibitor of C3 convertase, prevents spontaneous activation of alternative complement path
- C8 binding protein
What is the leading cause of death in pt’s with Paroxysmal Nocturnal Hemoglobinuria (PNH)?
Venous Thrombosis, often involving hepatic, portal, or cerebral veins

5-10% of patients w/ Paroxysmal Nocturnal Hemoglobinuria (PNH) are at risk for developing which hematopoietic disorders?
AML or a myelodysplastic syndrome
Which monoclonal antibody can be used in PNH to prevent conversion of C5 to C5a and reduce risk of venous thrombosis by 90%?
Eculizumab
How is the diagnosis of Paroxysmal Nocturnal Hemoglobinuria (PNH) made?
Flow cytometry to detect red cells deficient in GPI-linked proteins such as CD59
What are the secondary causes of the warm antibody type of immunohemolytic anemia?
- Autoimmune disorders
- Drugs
- Lymphoid neoplasms
Most of the causative antibodies of the warm antibody type of immunohemolytic anemia are of what class?
IgG
What occurs in the pathophysiology of warm antibody types of immunohemolytic anemias?
- IgG-coated red cells bind Fc receptors on phagocytes, which remove the red cell membrane via “partial” phagocytosis
- Loss of membrane creates spherocytes which are sequestered and destroyed in the spleen —> moderate splenomegaly
Explain how antigenic drugs can cause warm antibody type of immunohemoltyic anemias and what are 2 drugs this is commonly seen with?
- 1-2 weeks after initiating therapy w/ large IV doses of drugs such as penicillin or cephalosporin
- Drugs bind red cell membrane and antibodies can act as opsonins that promote extravascular hemolysis
What is the prototypical tolerance breaking drug responsible for warm antibody type of immunohemoltyic anemias; how does this occur?
- α-methyldopa
- Induces production of antibodies againt red cells antigens, particularly the Rh antigen
What are some conditions associated with microangiopathic hemolytic anemia?
- DIC = most common
- Thrombocytopenic purpura (TTP)
- Hemolytic-uremic syndrome (HUS)
- Malignant HTN
- SLE
- Disseminated cancer
What is the morphology of both red cells and neutrophils seen on a blood smear in megaloblastic anemia?
- Red cells = macrocytic and oval (macro-ovalocytes) w/ variation in size (anisocytosis) and shape (poikilocytosis)
- Neutrophils = larger than normal (macropolymorphonuclear) and show nuclear hypersegmentation, having 5+ nuclear lobes

Why is there pancytopenia in megaloblastic anemia if there are increased hematopoietic precursors being produced in the marrow?
Abnormal DNA synthesis causes most precursors to undergo apoptosis in the marrow
Pernicious anemia is a specific form of megaloblastic anemia caused by what?
Autoimmune gastritis impairiring production of IF needed for Vit B12 uptake
What is the proximate cause of anemia in vitamin B12 deficiency?
Lack of folate

What is thought to initiate the gastric mucosal injury underlying autoimmune gastritis and pernicious anemia?
Autoreactive T-cell response initiates the injury and triggers formation of autoantibodies

What are the characteristic morphological changes seen in the stomach of pt w/ autoimmune gastritis (pernicious anemia)?
- Fundic gland atrophy
- Intestinalization –> glandular epithelium undergoes metaplasia to mucus-secreting goblet cells that resemble the lining of the large intestine
Long-standing pernicious anemia causes what finding of the tongue?
Atrophic glossitis = beefy red tongue
Which sx’s of B12 deficiency respond to folic acid administration and which do not?
- Hematologic sx’s (anemia) may improve
- Neuro sx’s will NOT and may even worsen
Diagnosis of pernicious anemia is based on what 4 findings?
- Moderate to severe megaloblastic anemia
- Leukopenia w/ hypersegmented granulocytes
- Low serum B12
- ↑ levels of homocysteine and methylmalonic acid
Diagnosis of pernicious is confirmed how?
Parenteral B12 causes an outpouring of reticulocytes and a rise in hematocrit levels around 5 days after beginning administration
Elevated homocysteine levels as seen in vitamin B12 deficiency are a risk factor for what?
Atherosclerosis and thrombosis
Porphyria accumulation in the liver is associated with what conditions?
- Liver damage w/ hepatic insufficiency
and
- ↑ risk for hepatocellular carcinoma
What are the clinical signs/sx’s associated with chronic porphyrias?
- Skin = very sensitive to sunlight –> blistering, abnormal hair growth
- Teeth = staining
What are the clinical signs/sx’s associated with acute porphyrias?
- Referred pain from the thorax and abdomen
- Seizures, hallucinations, and general psychosis
Which lab values and clinical signs/sx’s distinguish a true folate deficiency from that of Vit B12 as a cause of megaloblastic anemia?
- Serum homocysteine levels are ↑, but [methylmalonate] = normal
- Neurological changes do NOT occur w/ pure folate deficiency
What is the effect of diseases with ineffective erythropoiesis leading to 2’ hemochromatosis (i.e., β-thalassemia) on hepcidin levels?
Suppresses hepatic hepcidin production, even when iron levels are high
What are the HCT, Hgb, serum iron, ferritin, TIBC, and hepcidin levels like with iron deficiency anemia?
- HCT, Hgb = ↓
- Serum iron = ↓
- Serum ferritin = ↓
- TIBC = ↑
- Serum hepcidin = ↓

What is a diagnostically significant finding in the bone marrow with iron deficiency anemia?
Dissapearance of stainable iron from macrophages; best assessed with Prussian blue stain on smear of aspirated marrow
What is seen morphologically on peripheral blood smear of iron deficiency anemia?
Red cells are hypochromic microcytic w/ modest poikilocytosis

The chronic illnesses associated w/ anemia of chronic disease can be grouped into what 3 categories?
- Chronic microbial infections, such as osteomyelitis, bacterial endocarditis, and lung abscess
- Chronic immune disorders, such as RA and regional enteritis
- Neoplasms, such as carcinomas of the lung and breast, and Hodgkin lymphoma
Which inflammatory mediator associated with anemia of chronic disease is responsible for the increased production of hepcidin?
IL-6
Which 2 lab values distinguish anemia of chronic disease from iron deficiency anemia?
High ferritin and low TIBC

Aplastic anemia is a syndrome characterized by what?
Chronic primary hematopoietic failure + attendant pancytopenia (anemia, neutropenia, and thrombocytopenia)
What is the inheritance of Fanconi anemia and the dominant clinical features?
- AR caused by defects in multiprotein complex required for DNA repair
- Marrow HYPOfunction early in life, often other congenital anomalies, such as hypoplasia of kidney and spleen
- Bone anomalies, most commonly of thumbs or radii
List 6 physical agents/infections which may cause aplastic anemia?
- Whole-body irradiation
- Viral infections
- Hepatitis (non-A,B,C, or G type)
- CMV
- EBV
- Herpes zoster (varicella zoster)
What are 2 types of mutations which are associated with adult-onset aplastic anemia?
- Inherited defects in telomerase
- Abnormally short telomeres
What are the 2 major etiologies which have been proposed for the pathogenesis of aplastic anemia?
- Extrinsic, immune-mediate suppression of amrrow progenitors thru activated TH1 cells producing IFN-y and TNF
- Intrinsic, abnormality of stem cells; may be antigenically altered via exposure to drugs, infectious agents, etc.

How is the diagnosis of aplastic anemia made and what are you looking for?
- Examination of the bone marrow via biopsy
- Markedly HYPOcellular BM largely devoid of hematopoietic cells; only fat cells, fibrous stroma, and scattered lymphocytes + plasma cells

What are the presenting signs/sx’s that may be seen with aplastic anemia?
- Anemia —> weakness, pallor, and dyspnea
- Thrombocytopenia –> petechiae and ecchymoses
- Neutropenia –> frequent/persistent minor infections or sudden onset chills, fever, and prostration
What is the morphology of the red cells in aplastic anemia; what is the rule?
- Slightly macrocytic and normochromic
- Reticulocytopenia is the rule
What is the treatment of choice for aplastic anemia; prognosis?
Bone marrow transplant; 5-year survival of 75%
Pure red cell aplasia may occur in association with what conditions?
- Thymoma
- Large, granular lymphocytic leukemia
- Drug exposures
- Autoimmune disorders
- Parvovirus B19

With the exception of parvovirus, most pure red cell aplasias have what type of basis?
Autoimmune
How does the pure red cell aplasia associated with Parvovirus differ in a healthy pt vs. pt with moderate/severe hemolytic anemia?
- Normal = the aplasia is transient and infection cleared 1-2 weeks
- Pt w/ moderate to severe hemolytic anemia, even a brief cessation of erythropoiesis results in rapid worsening of the anemia –> aplastic crisis
What is Myelophthisic anemia and the most common cause?
- Marrow failure due to space-occupying lesions replacing normal marrow elements
- Most commonly due to metastatic cancer, often carcinoma of the breast, lung, and prostate
Myelophthisic anemia is also a feature of which phase of myeloproliferative disorders?
Spent phase
What is the seen in both the marrow and peripheral blood with Myelophthisic anemia?
- Marrow distortion and fibrosis
- Abnormal release of erythroid precursors and immature granulocytic forms (leukoerythroblastosis)
- Appearance of tear-drop shaped red cells
How does chronic renal failure lead to anemia and what is the severity of the anemia proportional to?
- Due to diminished synthesis of EPO by the kidney
- Anemia tends to be proportional to the severity of the anemia


